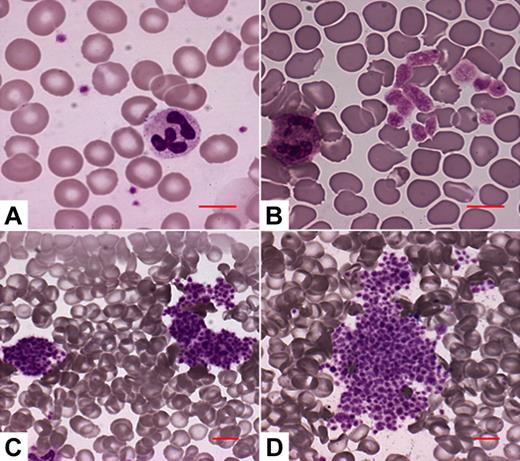
Figure 2. The 4 platelet morphology patterns identified in the VWD2B patients. (A) No abnormalities of platelet size or distribution. (B) Enlarged platelets, no platelet aggregates. (C) Some platelets are associated to form small platelet aggregates. (D) Most platelets are associated to form large platelet aggregates. Microscopy was performed through the Axioscope 2 Plus microscope (Carl Zeiss, Gottingen, Germany), using a 20×/0.50 Plan Neofluar or a 63×/1.25 Plan Neofluar oil-immersion objective (Carl Zeiss), and the Eukitt mounting medium (Bio-Optica, Milan, Italy). Images were acquired by the Axiocam MRc camera (Carl Zeiss) and the Axiovision 4.5 software (Carl Zeiss).

Abstract
Type 2B von Willebrand disease (VWD2B) is caused by an abnormal von Willebrand factor (VWF) with increased affinity for the platelet receptor glycoprotein Ib-α (GPIb-α) that may result in moderate to severe thrombocytopenia. We evaluated the prevalence and clinical and molecular predictors of thrombocytopenia in a cohort of 67 VWD2B patients from 38 unrelated families characterized by VWF mutations. Platelet count, mean platelet volume, and morphologic evaluations of blood smear were obtained at baseline and during physiologic (pregnancy) or pathologic (infections, surgeries) stress conditions. Thrombocytopenia was found in 20 patients (30%) at baseline and in 38 (57%) after stress conditions, whereas platelet counts were always normal in 16 patients (24%) from 5 families carrying the P1266L/Q or R1308L mutations. VWF in its GPIb-α–binding conformation (VWF–GPIb-α/BC) was higher than normal in all except the 16 cases without thrombocytopenia (values up to 6-fold higher than controls). The risk of bleeding was higher in patients with thrombocytopenia (adjusted hazard ratio = 4.57; 95% confidence interval, 1.17-17.90) and in those with the highest tertile of bleeding severity score (5.66; 95% confidence interval, 1.03-31.07). Prediction of possible thrombocytopenia in VWD2B by measuring VWF–GPIb-α/BC is important because a low platelet count is an independent risk factor for bleeding.
Introduction
Type 2B von Willebrand disease (VWD2B) is a rare autosomally inherited bleeding disorder (5%-8% of all VWD types), typically characterized by enhanced ristocetin-induced platelet aggregation (RIPA) in platelet-rich plasma (PRP).1 In VWD2B, von Willebrand factor (VWF) is normally synthesized and assembled by endothelial cells but has heightened platelet affinity when released into the circulation.2 Mutations, clustered in exon 28 of the VWF gene encoding the VWF A1 domain involved in VWF binding to the platelet receptor glycoprotein Ib alpha (GpIb-α), are responsible for this VWD2B defect.3-5 The gain of function of the VWF A1 domain creates the following conditions that may explain the bleeding tendency in these patients: (1) the high molecular weight (HMW), hemostatically most effective, VWF multimers are decreased in a patient's plasma; (2) thrombocytopenia may occur; and (3) platelets' GpIb-α receptors may be occupied by soluble VWF and become unable to interact with immobilized VWF exposed at the sites of injury.6 The plasma defect of the largest VWF multimers is thought to be the result of their removal from the circulation, consistent with the normal pattern in platelets and their transient appearance in plasma after 1-8-deamino-D-arginine vasopressin (DDAVP) administration.7,8 A wide degree of heterogeneity has been found in the VWF multimeric patterns in VWD2B,9 ranging from the complete loss of the largest multimers to a normal pattern in the VWD2B variant previously known as type 1 Malmö or New York.10-12
VWD2B patients who lack the HMW multimers may also have moderate to severe thrombocytopenia,13,14 sometimes associated with giant platelets and spontaneous platelet aggregates,15-17 and this can predispose to more severe bleeding. Thrombocytopenia in VWD2B can be overlooked, especially in children18-20 : it can be transient or persistent with variable platelet count on different occasions but usually worsens after conditions characterized by a long- or short-term rise in plasma VWF such as pregnancy,21,22 infections, surgeries,23 or DDAVP administration.24 The thrombocytopenia phenotype is mainly caused by the enhanced 2BVWF–GpIb-α interactions resulting from gain of function of the A1 domain, leading to spontaneous platelet aggregation in vitro and in vivo.15,16 More recently, abnormal megakaryocytopoiesis with severe thrombocytopenia was described in a family with VWD2B characterized by the R1308P substitution, suggesting a major role of the enhanced 2BVWF–GpIb-α interactions in platelet formation and release.25
No large studies on the effect of thrombocytopenia on the clinical manifestations of VWD2B patients have been performed so far. To determine the prevalence of thrombocytopenia, the associated clinical and molecular markers, and to assess the risk of bleeding associated with this complication, we have followed for 2 years 67 patients with identified VWF2B mutations. Genotypes and VWF measurements were related to platelet count and morphology. In these patients, thrombocytopenia was also evaluated after the occurrence of stress conditions, such as pregnancy, infection, and surgery, and was correlated with the frequency of bleeding episodes. Another aim of this study was to confirm in a large number of well-characterized patients whether or not VWF in its GPIb-α–binding conformation (VWF–GPIb-α/BC) measured by a nanobody26 helps to predict possible thrombocytopenia in VWD2B.
Methods
Clinical assessment of VWD2B patients
A cohort of 67 VWD2B patients regularly followed up by Hemophilia Centers in Milan and Vicenza (Italy) and Utrecht (The Netherlands) were evaluated at baseline and then prospectively at 3-month intervals during a follow-up period of 24 months (between October 1, 2005, and October 1, 2007).27,28 At baseline, a questionnaire originally devised to determine a bleeding severity score in VWD type 1 was administered to all patients.29 During follow-up, all patients were investigated during physiologic and pathologic stress conditions that might trigger thrombocytopenia by increasing plasma levels of VWF2B. Bleeding episodes were also recorded. A study of family members was also performed to evaluate phenotype heterogeneity within the same pedigree in 4 families characterized by the following VWD2B mutations: P1266L, R1306W, R1308L, and I1309V (data not shown).
Blood collection and laboratory methods
Patients who were informed about the anonymous uses of their data and on the purpose of the study gave informed consent in accordance with the Declaration of Helsinki. This study received Institutional Review Board approval from all 3 participating centers. Venous blood was obtained at each Hemophilia Center at baseline and at the time of visits during follow-up. Plasma samples were prepared and kept frozen at −40°C. The skin bleeding time was measured by the Simplate-II (Organon Teknika, Durham, NC), factor VIII (FVIII) by one-stage coagulometric assay, VWF: antigen (VWF:Ag) by commercial kits, or homemade enzyme-linked immunosorbent assay using anti-VWF polyclonal antibodies. VWF Ristocetin cofactor activity (VWF:RCo) was measured by aggregometry using formalin-fixed platelets from normal donors; when plasma VWF:RCo was less than 15 U/dL, VWD2B patients were further investigated using the more sensitive enzyme-linked immunosorbent assay VWF:RCo.30 RIPA was carried out in PRP by aggregometry, and changes in light transmission were inscribed in a potentiometric chart recorder. RIPA values were expressed as the minimal concentration of ristocetin giving 30% increase in transmission (normal range, 0.8-1.2 mg/mL ristocetin).1,28 The multimeric pattern of plasma VWF was evaluated centrally (Milan) by low-resolution gel electrophoresis using 0.9% low gelling temperature agarose.31 Four different patterns were identified in VWD2B patients (Figure 1): pattern A, all multimers present, as in normal persons; pattern B, partial loss of the HMW multimers; pattern C, complete loss of HMW multimers; pattern D, loss also of intermediate multimers. All the patients carried a mutation within the A1 domain of VWF. All identified mutations had been previously included in the International Society of Thrombosis and Hemostasis VWF database.32
The 4 multimeric patterns found in the entire cohort of VWD2B patients. Pattern A indicates all HMW multimers present, as in plasma of normal persons; pattern B, partial loss of the HMW multimers; pattern C, complete loss of HMW multimers; pattern D, loss of high and intermediate multimers. Pattern A is identical to that of normal plasma (NP).
The 4 multimeric patterns found in the entire cohort of VWD2B patients. Pattern A indicates all HMW multimers present, as in plasma of normal persons; pattern B, partial loss of the HMW multimers; pattern C, complete loss of HMW multimers; pattern D, loss of high and intermediate multimers. Pattern A is identical to that of normal plasma (NP).
Platelet count and morphology
The number of single platelets and their mean platelet volumes were measured by SYSMEX XE-2100-Hemocoulter (Sysmex, Kobe, Japan) immediately after blood withdrawal. VWD2B patients were considered as thrombocytopenic if their platelet counts were less than 140 × 103/μL (corresponding to the lower limit of normal range of the method) on at least 3 different measurements. To prevent bias in the morphologic evaluation, blood smears were evaluated blindly (by A.P. who was not aware of the VWD2B mutations). Four different morphologic patterns were identified in the VWD2B patients (Figure 2): pattern A, no abnormalities of platelet size or distribution; pattern B, enlarged platelets, no platelet aggregates; pattern C, platelets forming small aggregates; pattern D, platelets forming large aggregates.
The 4 platelet morphology patterns identified in the VWD2B patients. (A) No abnormalities of platelet size or distribution. (B) Enlarged platelets, no platelet aggregates. (C) Some platelets are associated to form small platelet aggregates. (D) Most platelets are associated to form large platelet aggregates. Microscopy was performed through the Axioscope 2 Plus microscope (Carl Zeiss, Gottingen, Germany), using a 20×/0.50 Plan Neofluar or a 63×/1.25 Plan Neofluar oil-immersion objective (Carl Zeiss), and the Eukitt mounting medium (Bio-Optica, Milan, Italy). Images were acquired by the Axiocam MRc camera (Carl Zeiss) and the Axiovision 4.5 software (Carl Zeiss).
The 4 platelet morphology patterns identified in the VWD2B patients. (A) No abnormalities of platelet size or distribution. (B) Enlarged platelets, no platelet aggregates. (C) Some platelets are associated to form small platelet aggregates. (D) Most platelets are associated to form large platelet aggregates. Microscopy was performed through the Axioscope 2 Plus microscope (Carl Zeiss, Gottingen, Germany), using a 20×/0.50 Plan Neofluar or a 63×/1.25 Plan Neofluar oil-immersion objective (Carl Zeiss), and the Eukitt mounting medium (Bio-Optica, Milan, Italy). Images were acquired by the Axiocam MRc camera (Carl Zeiss) and the Axiovision 4.5 software (Carl Zeiss).
Measurement of VWF in its binding conformation to GPIb-α
The VWF in its binding conformation to GPIb-α was measured in plasma by immunoadsorbent assay based on the nanobody AU/VWFa-11.26 This assay allows quantification of the abnormal VWF that circulates in plasma in a GpIb-α–binding conformation in vivo. In brief, AU/VWFa-11–coated microtiter wells were incubated with plasma samples diluted in phosphate-buffered saline. The amount of bound VWF was then measured by horseradish peroxidase–conjugated polyclonal antibodies against VWF. The slope of the initial linear part of the binding curve was calculated for each sample and for reference plasma. The ratio of the slope for the different plasma samples and the slope for reference plasma was subsequently calculated and designated as VWF in its GPIb-α–binding conformation (VWF–GPIb-α/BC). Normal values obtained on plasma samples from 40 normal persons were 0.70 plus or minus 0.13 (mean ratio ± SD). Data were also obtained from additional 36 patients with VWD types 1, 2A, or 2M all characterized by VWF mutations outside (VWD types 1 and 2A) or within (VWD type 2M) VWF A1 domain. VWF–GPIb-α/BC values were as follows: 0.30 plus or minus 0.25 in VWD1 (n = 12), 0.38 plus or minus 0.31 in VWD2A (n = 14), and 2.93 plus or minus 1.75 in VWD2M (n = 10). These data are used for comparison with results obtained in VWD2B patients enrolled in the study (for details, see Figure 5A).
Statistical analysis
Continuous variables were expressed as median and range. Comparison between groups was made by χ2 test, Mann-Whitney U test, or one-way analysis of variance, where appropriate. The monthly incidence of bleeding during follow-up (and its 95% confidence interval [CI]) in the whole cohort and in different subgroups was calculated by dividing the total number of first bleeding episodes by the total number of patient-months. For each patient, the observation period started at October 1, 2005, and ended at October 1, 2007 (if no bleeding episodes occurred) or at the time of the first bleeding episode. Bleeding-free survival according to platelets count at baseline (≥ 140 × 103/μL, < 140 × 103/μL) and to different tertiles of bleeding severity scores (< 4, 4-8, > 8) was calculated by the Kaplan-Meier method. The Cox proportional hazard model was performed, which allowed for adjustment for bleeding severity score and presence or absence of thrombocytopenia (1 for each other) and for age, sex, VWF:RCo divided in tertiles (> 40, 20-40, < 20 IU/dL) and VWF–GPIb-α/BC (< 1, 1-4, > 4). The final hazard ratio expresses the risk of bleeding of one group compared with the reference, adjusted for the other variables in the model. P ≤ .05 was taken as cutoff for statistical significance. Statistical analysis was performed using SPSS software package (release 15.0; SPSS, Chicago, IL).
Results
Demographic, genotypic, and phenotypic data of VWD2B patients
In the cohort of 67 VWD2B patients (38 families), 40 (60%) were females and 27 (40%) males. Results of bleeding severity score and VWF measurements are summarized in Table 1 according to the specific VWF gene mutations, all located in exon 28 encoding the VWF A1 domain. The bleeding severity score was higher than 1 (normal values from −1 to 0) in 60 patients (89%). Patients with the P1266Q mutation had the lowest scores (median, 0.5; range, 0-2), those with V1316M the highest (median, 13; range, 12-16). The bleeding time was prolonged (normal value, < 7 minutes) in 54 patients (79%), the lowest values being in P1266L (median, 5; range, 3-9), and the highest in V1316M (median, 31; range, 28-35). RIPA was enhanced in all the patients by diagnostic definition, whereas levels of VWF:RCo were only moderately reduced and were normal in 12 of 67 (18%) cases. VWF:Ag levels, normal in the majority of the cases, were used to calculate the VWF:RCo/Ag ratios, which were lower in the presence of defects of the HMW multimers. Results of multimeric analyses could be assembled into 4 different patterns (Figure 1). A normal multimeric pattern (pattern A) was found in the 16 patients with mutations P1266L/Q and R1308L. Partial loss of HMW multimers (pattern B) was found in the 12 patients with mutations H1268D, I1309V, and P1337L. Patterns C (complete loss of HMW multimers) and D (loss also of intermediate multimers) were found in 22 (R1306W, R1341Q/W) and 17 (R1308C, V1316M) cases, respectively. Plasma levels of factor VIII were normal or slightly reduced in the great majority of patients.
Platelet count at baseline and during physiologic or pathologic stress situations
At baseline, 20 of 67 patients (30%) had platelet count less than 140 × 103/μL on at least 3 different measurements. An inverse relationship between platelet count at baseline and bleeding severity score was observed: the median platelet count was 249 × 103/μL (range, 82-402; n = 21) in patients with bleeding severity score less than 4, 177 × 103/μL (range, 66-251; n = 24) in those with bleeding severity score 4 to 8, and 144 × 103/μL (range, 19-322; n = 22) in those with bleeding severity score more than 8 (Figure 3; 1-way analysis of variance: P < .001). During the 24-month follow-up, 31 patients were exposed to stress situations, including pregnancy (n = 6), infection (n = 12), and surgery (n = 13) (Table 2). During the last 3 months of pregnancy, 5 patients with mutations R1306W and R1308C had median values of 56 and 64 × 103/μL, respectively, whereas a normal platelet count was found in a pregnant woman with P1266Q. Infectious episodes included viral hepatitis C (n = 7), gastroenteritis (n = 3), and bacterial infection complicating local hematomas (n = 2). Ten patients with mutations H1268D, R1306W, R1308C, I1309V, V1316M, and R1341Q/W developed thrombocytopenia during these episodes with trough values ranging from 21 to 131 × 103/μL, whereas 2 patients with the R1308L mutation had no fall in platelet count. Six major surgical procedures were performed in the gastrointestinal tract for cancer or recurrent bleeding for angiodysplasia; caesarian sections, hysterectomy, and tonsillectomy were performed in 4, 2, and 1 case, respectively. Postsurgical thrombocytopenia was observed in 11 of 13 cases; however, platelet count remained normal in 2 patients with the P1266L and R1308L mutations. DDAVP is not recommended in VWD2B,28 and it was therefore given only to 3 patients with P1266L (formerly diagnosed as type 1 Malmö or New York) or R1308L mutations10,33 : none of them developed thrombocytopenia after administration of the drug. To sum up, 26 of 34 patients who were exposed to stress situations developed transient thrombocytopenia. None of the 8 patients with P1266Q/L or R1308L mutations exposed to stress situations, including DDAVP infusion, developed thrombocytopenia.
Distribution of platelet counts according to bleeding severity score in the 67 patients enrolled in the study. Bleeding severity score was obtained at enrollment, and platelet counts were measured at baseline. Each box plot represents interquartile range with median value (white line in the middle) and 95% intervals. ○ indicates an outlier.
Distribution of platelet counts according to bleeding severity score in the 67 patients enrolled in the study. Bleeding severity score was obtained at enrollment, and platelet counts were measured at baseline. Each box plot represents interquartile range with median value (white line in the middle) and 95% intervals. ○ indicates an outlier.
Platelet volume and morphology in relation to VWF–GPIb-α/BC values
Morphologic analysis of peripheral blood smears identified 4 different patterns (Figure 2). Normal pattern (A) was found in the 18 patients with the P1266Q/L, R1308L, or P1337L mutations; pattern B (enlarged platelets without aggregates) was present in the 20 patients with H1268D, R1306W, and R1341Q; patterns C and D, with evidence of small or large platelet aggregates, were found in the 29 patients with R1308C, I1309V, V1316M, and R1341W (Table 2). Platelet aggregates correlated with a lower platelet count at baseline. Enlarged platelets at morphologic analysis were globally present in 24 patients, who corresponded to those who had increased mean platelet volume as measured by automated counters. The most severe thrombocytopenia at baseline and after stress conditions was observed in VWD2B patients carrying V1316M mutation.
VWF–GPIb-α/BC was measured in the VWD2B cases enrolled in the study, all characterized by mutations within VWF A1 domain. The localization of the gain-of-function mutations responsible for the 67 cases of VWD2B are shown in Figure 4: for comparison, also the sites of the loss-of-function mutations responsible for VWD2M are reported. Values of VWF–GPIb-α/BC were high in all but the 16 cases with mutations P1266L/Q, R1308L, with values up to 6 times higher than those of controls (Figure 5A). Interestingly, high VWF–GPIb-α/BC values were also found in 10 VWD2M patients with mutations (delD1277, R1315C/L, Y1321C, R1374H) within VWF A1 domain; on the other hand, values lower than normal were found in VWD types 1 and 2A, characterized by mutations outside VWF A1 domain.
Localization of the 8 point mutations found in the 67 VWD2B patients within the VWFA1 domain. We are using the modeling derived by the crystal structure of the VWF A1 domain.38 Seven gain-of-function VWD2B point mutations (H1268D, R1306Q, R1308C/L, I309V, V1316H, P1337L, R1341Q/W) are indicated in red, whereas the P1266L/Q is shown in yellow. Note that point mutation R1308 is indicated with 2 different colors according to the different amino acid substitutions: R1308C (red) and R1308L (yellow). For comparison, 4 loss-of-function mutations (delD1277, R1315C/L, Y1321C, R1374H) that were detected in patients with VWD2M are indicated in green. Note that both gain-of-function (VWD2B) and loss-of-function (VWD2M) mutations were characterized by VWF–GPIb-α/BC > 1. Only 2 point mutations, 1 with 2 different amino acid substitutions (P1266L/Q) and the other with 1 specific amino acid (R1308L), are indicated in yellow because they showed VWF–GPIb-α/BC values similar to normal controls (Table 2; Figure 5A).
Localization of the 8 point mutations found in the 67 VWD2B patients within the VWFA1 domain. We are using the modeling derived by the crystal structure of the VWF A1 domain.38 Seven gain-of-function VWD2B point mutations (H1268D, R1306Q, R1308C/L, I309V, V1316H, P1337L, R1341Q/W) are indicated in red, whereas the P1266L/Q is shown in yellow. Note that point mutation R1308 is indicated with 2 different colors according to the different amino acid substitutions: R1308C (red) and R1308L (yellow). For comparison, 4 loss-of-function mutations (delD1277, R1315C/L, Y1321C, R1374H) that were detected in patients with VWD2M are indicated in green. Note that both gain-of-function (VWD2B) and loss-of-function (VWD2M) mutations were characterized by VWF–GPIb-α/BC > 1. Only 2 point mutations, 1 with 2 different amino acid substitutions (P1266L/Q) and the other with 1 specific amino acid (R1308L), are indicated in yellow because they showed VWF–GPIb-α/BC values similar to normal controls (Table 2; Figure 5A).
Values of VWF–GPIb-α/BC and correlation with platelet count. (A) Distribution of the values of VWF–GPIb-α/BC as detected by nanobody in 6 different groups of persons (from the left to the right): 40 normal subjects (indicated as normal controls); 12 VWD1 patients with multimeric pattern A (VWD1 HMWM [A]); 14 VWD2A patients with multimeric patterns C or D (VWD2A no HMWM [C-D]); 16 VWD2B patients with P1266Q/L and R1308L mutations with multimeric pattern A (VWD2B HMWM [A]); 51 VWD2B with multimeric patterns B or C or D (VWD2B no HMWM [B, C, D]); 10 VWD2M patients with multimeric pattern B (VWD2M no HMWM [B]). Note that VWF–GPIb-α/BC is lower than normal in VWD1 and VWD2A with mutations outside VWF A1 domain and is higher than normal in VWD2B and VWD2M with mutations within VWF A1 domain. Interestingly, the gain-of-function P1266Q/L and R1308L mutations characterized by the presence of all the multimers (pattern A) show VWF–GPIb-α/BC values similar to controls. (B) Relationship between VWF–GPIb-α/BC values by nanobody (vertical axis) and platelet count at baseline (horizontal axis) in the 67 patients with VWD2B. Patients with normal HMW multimers and P1266Q/L and R1308L mutations have normal values of VWF–GPIb-α/BC (○), whereas VWD2B patients with loss of HMW multimers and H1268D, R1306Q, R1308C/L, I309V, V1316H, P1337L, and R1341Q/W mutations have increased values of VWF–GPIb-α/BC (●). Note that an inverse relationship is present mainly in the second group of patients.
Values of VWF–GPIb-α/BC and correlation with platelet count. (A) Distribution of the values of VWF–GPIb-α/BC as detected by nanobody in 6 different groups of persons (from the left to the right): 40 normal subjects (indicated as normal controls); 12 VWD1 patients with multimeric pattern A (VWD1 HMWM [A]); 14 VWD2A patients with multimeric patterns C or D (VWD2A no HMWM [C-D]); 16 VWD2B patients with P1266Q/L and R1308L mutations with multimeric pattern A (VWD2B HMWM [A]); 51 VWD2B with multimeric patterns B or C or D (VWD2B no HMWM [B, C, D]); 10 VWD2M patients with multimeric pattern B (VWD2M no HMWM [B]). Note that VWF–GPIb-α/BC is lower than normal in VWD1 and VWD2A with mutations outside VWF A1 domain and is higher than normal in VWD2B and VWD2M with mutations within VWF A1 domain. Interestingly, the gain-of-function P1266Q/L and R1308L mutations characterized by the presence of all the multimers (pattern A) show VWF–GPIb-α/BC values similar to controls. (B) Relationship between VWF–GPIb-α/BC values by nanobody (vertical axis) and platelet count at baseline (horizontal axis) in the 67 patients with VWD2B. Patients with normal HMW multimers and P1266Q/L and R1308L mutations have normal values of VWF–GPIb-α/BC (○), whereas VWD2B patients with loss of HMW multimers and H1268D, R1306Q, R1308C/L, I309V, V1316H, P1337L, and R1341Q/W mutations have increased values of VWF–GPIb-α/BC (●). Note that an inverse relationship is present mainly in the second group of patients.
In patients with loss of HMW multimers, values greater than 1.0 were inversely related with thrombocytopenia at baseline (Figure 5B, R2 = 0.537) and predicted the occurrence of thrombocytopenia after exposure to stress. All the 16 patients with the P1266Q/L and R1308L mutations had the same phenotype, ie, normal levels of VWF–GPIb-α/BC, normal platelet count before and after stress, normal platelet morphology, and a normal multimeric pattern.
The variability of laboratory parameters within family members was assessed by providing details on 4 large VWD2B families characterized by 4 different mutations (P1226L, R1306W, R1308L, and I1309V): some phenotypic heterogeneity was found within the affected members, but the plasma multimeric pattern, occurrence of thrombocytopenia, and results of VWF–GPIb-α/BC were consistent in these VWD2B pedigrees (data not shown).
VWD2B patients with normal multimeric pattern and platelet count
As mentioned above, 16 patients (24%) from 5 unrelated families had a normal multimeric pattern and no thrombocytopenia before and after stress conditions. Besides mutation R1308L, found in one family (6 patients),33 more than 1 mutation was found in the remaining 4 families (10 patients), but all shared a substitution of proline 1266. The following nucleotide changes were identified: 3692A>C (N1231T), 3789G>A, 3797C>A (P1266Q) in families 1 and 2, 3686T>G (V1229G), 3692A>C (N1231T), 3735G>A, 3789G>A, 3797C>T (P1266L) in family 3, and 3789G>A, 3797C>T (P1266L) in family 4, indicating gene conversion with pseudogene.34 The data of these 16 patients are given in detail in Table 3: none of these patients characterized by enhanced RIPA, normal multimers, normal baseline platelet count, and morphology had increased values of VWF–GPIb-α/BC (median ratio, 0.59; range, 0.32-1.09), as shown in Figure 5A,B. Eight of these patients underwent a stress situation during follow-up without developing thrombocytopenia. The bleeding severity score was extremely heterogeneous (median, 2; range, 0-16), being abnormal in 11 of 16 (69%).
Thrombocytopenia and risk of bleeding and in VWD2B
During the 24-month follow-up, 29 of 67 VWD2B patients (43%) experienced at least 1 bleeding episode for a total of 73, mainly mucosal: 53% epistaxis, 32% gastrointestinal bleeding, 10% menorrhagia, 3% gum bleeds. Muscle hematomas were very rare (2%). The overall incidence of bleeding was 2.7% patient months (95% CI, 1.7%-3.7%). The main clinical and laboratory features of the 2 groups of patients with platelet count higher or lower than 140 × 103/μL are summarized in Table 4. Patients with thrombocytopenia at baseline showed an approximately 8-fold higher monthly incidence of bleeding than those with normal platelet count. Bleeding-free survival (Kaplan-Meier method) was different in the 2 groups of patients with platelet count higher or lower than 140 × 103/μL (Figure 6A; log-rank test: P < .001) and in those with bleeding severity score less than 4, 4 to 8, and more than 8 (Figure 6B; log-rank test: P = .003). The probability to be free of bleeding at 12 months was 79% for patients without thrombocytopenia and 20% for those with thrombocytopenia.
Cumulative survival according to platelet count and bleeding score. Bleeding-free survival curves calculated according to platelet count assessed at baseline (A) and to bleeding severity score (B) of the 67 patients with VWD2B. In panel A, 2 groups of patients are represented according to absence (≥ 140 × 103/μL;dashed line) or presence (< 140 × 103/μL; solid line) of thrombocytopenia. In panel B, 3 groups of patients are represented according to tertiles of bleeding severity score, ie, < 4 (small dashed line), 4-8 (big dashed line), more than 8 (solid line). In all curves, each step represents a bleeding event.
Cumulative survival according to platelet count and bleeding score. Bleeding-free survival curves calculated according to platelet count assessed at baseline (A) and to bleeding severity score (B) of the 67 patients with VWD2B. In panel A, 2 groups of patients are represented according to absence (≥ 140 × 103/μL;dashed line) or presence (< 140 × 103/μL; solid line) of thrombocytopenia. In panel B, 3 groups of patients are represented according to tertiles of bleeding severity score, ie, < 4 (small dashed line), 4-8 (big dashed line), more than 8 (solid line). In all curves, each step represents a bleeding event.
The adjusted hazard ratio for bleeding was approximately 6-fold higher in patients who had a bleeding severity score higher than 8 and 5 times higher in those with platelet count less than 140 × 103/μL, compared with the corresponding reference groups (Table 5). VWF:RCo levels were milder predictors of bleeding in these patients on multivariate analysis. Crude hazard ratio for bleeding in the group of patients with VWF–GPIb-α/BC > 4.0 was increased compared with the group with values less than 1.0 (4.35; 95% CI, 1.41-13.42), but this difference disappeared after adjustment, perhaps because of the strong correlation between VWF–GPIb-α/BC and thrombocytopenia. The median number of individual bleeding episodes was significantly higher in patients with thrombocytopenia than in those without (2; range, 0-7 vs 0; range, 0-4; P < .001).
Discussion
This study investigated the prevalence of thrombocytopenia, its clinical and molecular predictors, and the risk of bleeding in a cohort of VWD2B patients characterized in terms of VWF mutations. Patients were investigated at the time of enrollment using the same questionnaire developed to calculate the bleeding severity score in VWD type 1.27,29 The bleeding severity score was higher than normal in the majority of patients (89%). Patients with the V1316M mutation had remarkably high scores, which correlated with the abnormal laboratory phenotype: the same patients had also very prolonged bleeding times (> 30 minutes). Although RIPA was by definition enhanced in all patients, VWF:RCo levels were only moderately reduced and normal in a substantial number of cases and were milder predictors of the risk of bleeding. Moreover, the VWF:RCo/VWF:Ag ratios were not invariably lower than 0.7 as typically observed in VWD types 2A and 2M resulting from dysfunctional VWF13,14,28 : normal or reduced ratios were determined by the presence or the absence of HMW multimers, respectively. In agreement with previous studies,9 the multimeric pattern of plasma VWF was highly heterogeneous and cannot be used for the diagnosis of VWD2B. Therefore, the only specific assay remains RIPA in patients' PRP.28 Factor VIII levels were normal in most VWD2B, consistently with the very low frequency of soft tissue bleeding (hematomas and hemarthroses) in these patients.
Both the prevalence of thrombocytopenia and its role on the bleeding tendency of VWD2B patients were not well established so far. We found that bleeding severity score was inversely related to platelet count at baseline. During the 24-month follow-up, platelet count were obtained in all the patients both at baseline and during physiologic or pathologic stress conditions all associated with a short- or long-term rise of plasma VWF. Consistent with previous observations,9,13,14,33 platelet count were highly variable in VWD2B patients. The prevalence of patients with thrombocytopenia was only 30% at baseline but became almost double (58%) when patients were exposed to stress conditions. Among the 34 exposed patients, 26 (76%) developed transient thrombocytopenia. However, there were 16 patients from 5 unrelated families who always had a normal platelet count, both before and during stress conditions, including DDAVP. This therapeutic approach is usually not recommended in VWD2B28 but has been used in patients with P1266L or R1308L mutations10,33 : we confirmed that none of them developed thrombocytopenia after administration of the drug. This behavior was strictly correlated to genotype because these patients carried 3 mutations only (P1266Q/L or R1308L). In addition, they all had a normal multimeric pattern in plasma, like the patients previously identified as VWD type 1 Malmö/New York variants.10-12 These variants were considered very rare so far: this study indicates that patients with VWD2B Malmö/New York are not so rare, they only need to be identified by a RIPA assay. Moreover, we could recently show that both mutations P1266L/Q are associated with VWD2B Malmö/New York phenotype and that both mutations are the result of gene conversion between the VWF gene and its pseudogene.34 The finding of a bleeding score higher than 4 in several members of families with mutations localized at position 1266 as well as the demonstration of enhanced interaction with GpIb-α of this P1266L VWF mutant35 makes the hypothesis of a polymorphism improbable. Specific amino acid substitutions are probably critical for some VWD2B phenotypes: 12 of 16 patients with normal multimers, no thrombocytopenia but increased RIPA have substitutions with leucine at positions P1266 and R1308. In this cohort of patients, platelet morphology was extremely heterogeneous, spanning from normal to large platelets with or without aggregate formation. As previously observed, platelet aggregates in the blood smears correlated with a lower platelet count at baseline.15,16 Nurden et al also evaluated platelet morphology by electron microscopy in VWD2B patients and found some ultrastructural abnormalities.36
Another aim of this study was to confirm in a large series of patients the clinical significance of the measurement of VWF–GPIb-α/BC. In addition to the few cases with VWD2B and thrombotic thrombocytopenic purpura originally reported,26 the VWF–GPIb-α/BC was investigated only in another study on the effect of exercise on VWF. This investigation was carried out in patients with VWD type 1 and in 9 VWD2B patients with 4 different mutations (H1268N, R1306W, V1316M, R1341L)37 : there was a significant postexercise increase in VWF–GPIb-α/BC in both the control group and VWD2B but not in VWD type 1. In our study, VWF–GPIb-α/BC levels were increased in all but 16 cases with mutations P1266L/Q and R1308L, with values ranging from 2 to 6 times higher than normal. Indeed, assessment of VWF–GPIb-α/BC values was important for further characterization of VWD2B patients. In patients with loss of HMW multimers, values greater than 1 correlated with thrombocytopenia at baseline and predicted the development of thrombocytopenia after stress conditions. All the patients who had normal results on VWF–GPIb-α/BC carried the P1266Q/L or R1308L mutations, and, more importantly, the same phenotype, ie, normal platelet count both before and after stress, normal platelet morphology, and an intact multimeric pattern in plasma. Therefore, VWF–GPIb-α/BC, as tested by nanobody, is useful to predict thrombocytopenia in VWD2B patients after finding an enhanced RIPA test.
Moreover, in this study, we could confirm that VWF–GPIb-α/BC values were lower than normal not only in VWD types 1 but also in VWD2A, at least in those cases who are characterized by mutations outside VWF A1 domain. Interestingly, we could find, for the first time, values higher than normal in 10 VWD2M patients with mutations within VWF A1 domain (delD1277, R1315C/L, Y1321C, R1374H). These findings point out a major role for the nanobody assay in the diagnosis of VWD types because VWF–GPIb-α/BC values are always high in case of both gain-of-function (VWD2B) and loss-of-function (VWD2M) mutations within VWF A1 domain. Therefore, high values of VWF–GPIb-α/BC together with enhanced RIPA suggests VWD2B with possible thrombocytopenia; high values of VWF–GPIb-α/BC plus impaired RIPA suggests VWD2M; normal values of VWF–GPIb-α/BC plus enhanced RIPA, such as observed in certain P1266L/Q and R1308L mutations, suggests VWD2B without thrombocytopenia. We do not have definite explanations for the normal values of VWF–GPIb-α/BC observed in the 16 VWD2B patients with mutations P1266L/Q and R1308L. According to the observations found in several studies on the crystal structure of this complex,38 we can only postulate that specific amino acid substitutions (ie, leucine) might induce significant changes of the electrostatic interactions between mutated VWF A1 domain and GPIb-α.
Several authors reported a wide degree of heterogeneity in the clinical and laboratory features of affected members within the same VWD2B families.39-41 In this study, this heterogeneity was evaluated in 4 families with mutations P1226L, R1306W, R1308L, or I1309V. In these families, the VWF defects could be investigated not only in plasma1,9-11,33 but also by expression studies in vitro3,9,12,33 that gave homogeneous results. Despite some phenotypic heterogeneity observed within the affected members, the plasma multimeric pattern, occurrence of thrombocytopenia, and results of VWF–GPIb-α/BC were consistent in these VWD2B mutations.
Finally, we investigated whether or not thrombocytopenia associated with VWD2B was fromVWD2B patients only when plasma levels of mutant VWF are raised by physiologic and independent risk factor for bleeding in these patients. The bleeding-free survival curves differed significantly in the group of VWD2B with or without thrombocytopenia, and the risk of bleeding in patients with thrombocytopenia was almost 5 times higher than that of patients with a normal platelet count, even after correction for confounders. Perhaps these patients might deserve a trial with drugs inhibiting the heightened interaction between their abnormal VWF and platelet GPIb-α,42,43 to evaluate whether or not an increase in platelet count can be obtained during bleeding episodes or when they need invasive procedures.
In conclusion, thrombocytopenia is triggered in the majority pathologic stress situations. However, there is a group of patients with normal multimers who never develop thrombocytopenia. VWF–GPIb-α/BC as tested by nanobody can be a useful marker to further characterize VWD2B patients diagnosed by enhanced RIPA because it is always associated with loss of HMW multimers, large platelet volumes, and development of thrombocytopenia either in the absence or during stress situations. Thrombocytopenia is an independent risk factor for bleeding in patients with VWD2B.
An Inside Blood analysis of this article appears at the front of this issue.
Preliminary data were presented in part at the annual meeting of the American Society of Hematology, Orlando, FL, December 9-16, 2006, and discussed at the International Society of Thrombosis and Hemostasis-Scientific and Standardization Committee Subcommittee on von Willebrand Factor, Vienna, Austria, July 4, 2008.
The publication costs of this article were defrayed in part by page charge payment. Therefore, and solely to indicate this fact, this article is hereby marked “advertisement” in accordance with 18 USC section 1734.
Acknowledgments
The authors thank Rosanna Garavaglia who followed up the patients; biologists Giovanna Cozzi, Silvia La Marca, Margherita Punzo, and Valentina Rubini for the assays performed to diagnose VWD2B; Evelyn Groot who performed in Utrecht most of the assays to test VWF-GPIb-α/BC in additional patients with VWD; Zaverio M. Ruggeri for his helpful thoughts and suggestions on discussion of the data about molecular mechanisms of VWD2B; Carlo Balduini for the critical revision of the manuscript; and Luigi Flaminio Ghilardini for illustration work.
This work was supported in part by a grant from the Italian Ministry of Health (A.B.F., P.M.M.).
Authorship
Contribution: A.B.F. and P.G.D.G. were responsible for study initiation and coordination; A.B.F., P.M.M., G.C., L.B., P.B., M.T.C., A.P., P.J.L., and P.G.D.G. were involved in study design, data collection, and performing laboratory analyses; G.C., M.T.C., and L.B. were responsible for laboratory data of phenotype and genotype; A.P. was responsible for morphology of platelets; P.J.L. was responsible for setting up the assay of nanobody; P.B. was responsible for statistical analyses; A.B.F. and P.M.M. wrote the manuscript; G.C., L.B., P.B., A.P., P.J.L., and P.G.D.G. were responsible for revisions of draft manuscripts; and all authors were responsible for approval of the final manuscript.
Conflict-of-interest disclosure: The authors declare no competing financial interests.
Correspondence: Augusto B. Federici, Angelo Bianchi Bonomi Hemophilia Thrombosis Center, Department of Medicine and Medical Specialties, Istituti di Ricovero e Cura a Carattere Scientifico Maggiore Hospital, Mangiagalli, Regina Elena, Foundation and University of Milan, Via Pace, 9, 20122 Milan, Italy; e-mail: augusto.federici@unimi.it.




![Figure 5. Values of VWF–GPIb-α/BC and correlation with platelet count. (A) Distribution of the values of VWF–GPIb-α/BC as detected by nanobody in 6 different groups of persons (from the left to the right): 40 normal subjects (indicated as normal controls); 12 VWD1 patients with multimeric pattern A (VWD1 HMWM [A]); 14 VWD2A patients with multimeric patterns C or D (VWD2A no HMWM [C-D]); 16 VWD2B patients with P1266Q/L and R1308L mutations with multimeric pattern A (VWD2B HMWM [A]); 51 VWD2B with multimeric patterns B or C or D (VWD2B no HMWM [B, C, D]); 10 VWD2M patients with multimeric pattern B (VWD2M no HMWM [B]). Note that VWF–GPIb-α/BC is lower than normal in VWD1 and VWD2A with mutations outside VWF A1 domain and is higher than normal in VWD2B and VWD2M with mutations within VWF A1 domain. Interestingly, the gain-of-function P1266Q/L and R1308L mutations characterized by the presence of all the multimers (pattern A) show VWF–GPIb-α/BC values similar to controls. (B) Relationship between VWF–GPIb-α/BC values by nanobody (vertical axis) and platelet count at baseline (horizontal axis) in the 67 patients with VWD2B. Patients with normal HMW multimers and P1266Q/L and R1308L mutations have normal values of VWF–GPIb-α/BC (○), whereas VWD2B patients with loss of HMW multimers and H1268D, R1306Q, R1308C/L, I309V, V1316H, P1337L, and R1341Q/W mutations have increased values of VWF–GPIb-α/BC (●). Note that an inverse relationship is present mainly in the second group of patients.](https://ash.silverchair-cdn.com/ash/content_public/journal/blood/113/3/10.1182_blood-2008-04-152280/5/m_zh80240827590005.jpeg?Expires=1771136146&Signature=H6eEKEsMGA6U2MTiSQtTb5mtjh8-6O~GhAMZ05u9wghU074zKOF6x~1NV5s9fZROC5vyeZ9h3ld3BpHp~KzEcxk282ELh5y6U8gGYW2y9BcuQns0W~rQy4qOiQ-~hq5G94puALnhmxU2~ANEXoG~cT9LOBDWGSA4CD5lMPozpB6JK8I2Ik1HxKdWHcOYV5qDgPlnIkkt-9QOKy33jeZecjnmRAgSYaIbI5mWQUnOOiXufA9he846wufm61d2BWq8dFIEC8gGw58TN0sXUJMr2rcV8UlPTk458HmDw1swMVqi6TQz9t0C-F22-JtysnJHYTM2TKFYG0BN1GFgs8LW4Q__&Key-Pair-Id=APKAIE5G5CRDK6RD3PGA)

![Figure 5. Values of VWF–GPIb-α/BC and correlation with platelet count. (A) Distribution of the values of VWF–GPIb-α/BC as detected by nanobody in 6 different groups of persons (from the left to the right): 40 normal subjects (indicated as normal controls); 12 VWD1 patients with multimeric pattern A (VWD1 HMWM [A]); 14 VWD2A patients with multimeric patterns C or D (VWD2A no HMWM [C-D]); 16 VWD2B patients with P1266Q/L and R1308L mutations with multimeric pattern A (VWD2B HMWM [A]); 51 VWD2B with multimeric patterns B or C or D (VWD2B no HMWM [B, C, D]); 10 VWD2M patients with multimeric pattern B (VWD2M no HMWM [B]). Note that VWF–GPIb-α/BC is lower than normal in VWD1 and VWD2A with mutations outside VWF A1 domain and is higher than normal in VWD2B and VWD2M with mutations within VWF A1 domain. Interestingly, the gain-of-function P1266Q/L and R1308L mutations characterized by the presence of all the multimers (pattern A) show VWF–GPIb-α/BC values similar to controls. (B) Relationship between VWF–GPIb-α/BC values by nanobody (vertical axis) and platelet count at baseline (horizontal axis) in the 67 patients with VWD2B. Patients with normal HMW multimers and P1266Q/L and R1308L mutations have normal values of VWF–GPIb-α/BC (○), whereas VWD2B patients with loss of HMW multimers and H1268D, R1306Q, R1308C/L, I309V, V1316H, P1337L, and R1341Q/W mutations have increased values of VWF–GPIb-α/BC (●). Note that an inverse relationship is present mainly in the second group of patients.](https://ash.silverchair-cdn.com/ash/content_public/journal/blood/113/3/10.1182_blood-2008-04-152280/5/m_zh80240827590005.jpeg?Expires=1771136147&Signature=kcWIiFoNiUkEto4CCffkvj-zrn1ZCm5PQ6aTZ8wm2y9EFwYfmGmLDnH59ZIhL-OouWSQF-yp9fgJ~5QStT0p56Tha21XxagZriat2OU5a6hMzdVdmjtXKr4qnzbfZwcPwOyXzhl96AVu5WOXb2IqVGa-auOEy7uQQq-8UZIxDCFRIU1QD9PhtlZl2jCCUFdGH8lqcOeitShPXFcQRSl1dVxyZWVOmwGeVw1IKsZ1YKAUD5dLkwowcr1QyPRp3zteBdlRF~vXdIZOGS1e3HneuLKMTfhJewoOOI0g2GWUsaX4i~zQOLzn9yBOj1Yo5YzpiRAS9CJWr3wU6MHHNflR1g__&Key-Pair-Id=APKAIE5G5CRDK6RD3PGA)
